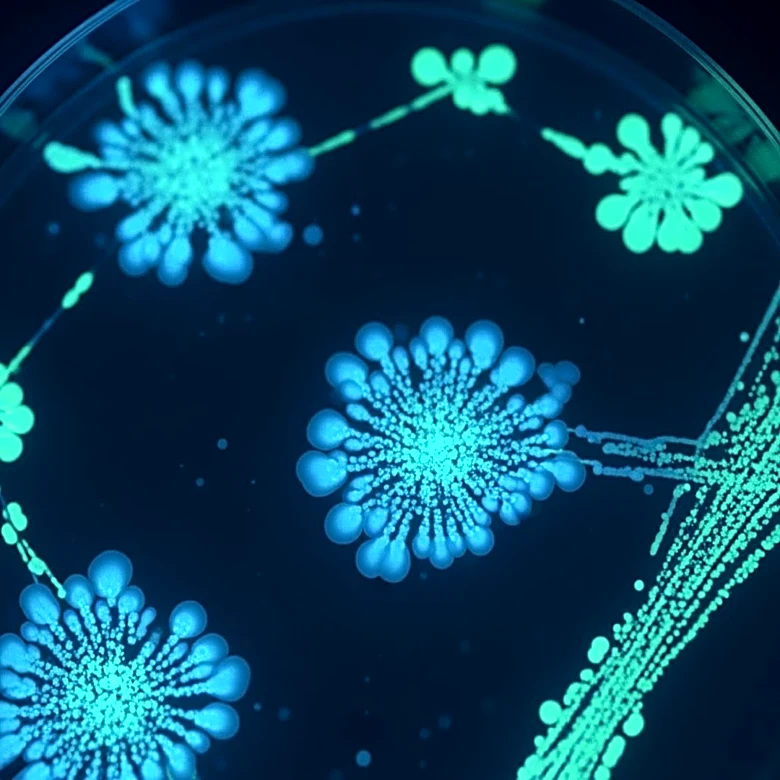
Researchers Discover Bacteria That Eradicates Tumors in Mice

What's Happening?
Researchers from the University of Rochester have identified a new mechanism for methane formation in the open ocean, which could intensify as the planet warms. Methane, a potent greenhouse gas, is being produced by certain bacteria in oxygen-rich ocean waters
under conditions of phosphate limitation. This discovery challenges previous assumptions that methane formation occurs only in oxygen-free environments. The study suggests that as climate change warms the ocean, nutrient mixing may decrease, creating ideal conditions for methane-producing microorganisms. This could lead to increased methane emissions, contributing to a harmful feedback loop of global warming.
Why It's Important?
The discovery of this methane source is crucial as it reveals a previously unaccounted factor in climate change models. Methane emissions from the ocean could significantly impact global warming predictions, necessitating updates to climate models to include this feedback loop. Understanding these processes is vital for accurate forecasting and developing effective climate policies. The findings underscore the complexity of oceanic systems and their role in climate dynamics, highlighting the need for comprehensive research and international collaboration to address climate change effectively.
What's Next?
Researchers will likely focus on refining climate models to incorporate this new methane source and its potential impact on global warming. Further studies are needed to understand the extent of methane emissions and their implications for climate policy. International efforts may be required to address oceanic methane emissions, potentially leading to new regulations and agreements. The scientific community will continue to explore the interactions between oceanic processes and climate change, aiming to develop strategies to mitigate these effects.
Beyond the Headlines
The discovery raises questions about the interconnectedness of oceanic and atmospheric systems and the challenges in predicting climate change. It highlights the importance of interdisciplinary research in understanding complex environmental processes. The findings may influence future environmental policies and international agreements on climate change mitigation.